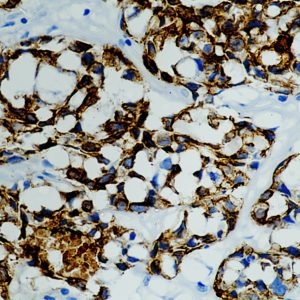
AMC59
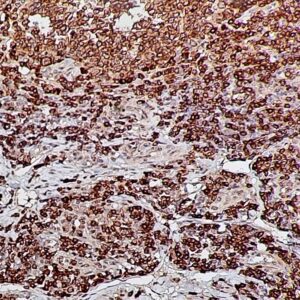
IHC on Appendicitis Tissue

C
Showing 21–40 of 234 resultsSorted by latest
-

Anti-CD103
Price range: $269.00 through $1,105.00 Select options This product has multiple variants. The options may be chosen on the product page -

Anti-CD162
Price range: $269.00 through $1,289.00 Select options This product has multiple variants. The options may be chosen on the product page -

Anti-CD95
Price range: $269.00 through $1,180.00 Select options This product has multiple variants. The options may be chosen on the product page -

Anti- CD269
Price range: $269.00 through $1,289.00 Select options This product has multiple variants. The options may be chosen on the product page -

Anti-CPA1
Price range: $269.00 through $1,289.00 Select options This product has multiple variants. The options may be chosen on the product page -
Anti-CD11b
Price range: $269.00 through $900.00 Select options This product has multiple variants. The options may be chosen on the product page -
Anti-CD79a
Price range: $269.00 through $1,580.00 Select options This product has multiple variants. The options may be chosen on the product page -

Anti-Cyclin B1
Price range: $269.00 through $1,015.00 Select options This product has multiple variants. The options may be chosen on the product page -

Anti-CD31
Price range: $269.00 through $1,249.00 Select options This product has multiple variants. The options may be chosen on the product page -

Anti-CTLA-4
Price range: $269.00 through $1,225.00 Select options This product has multiple variants. The options may be chosen on the product page -

Anti-CA-IX
Price range: $269.00 through $1,019.00 Select options This product has multiple variants. The options may be chosen on the product page -

Anti-CD64
Price range: $269.00 through $1,029.00 Select options This product has multiple variants. The options may be chosen on the product page -

Anti-CD8A, Clone C8/468
Price range: $269.00 through $1,205.00 Select options This product has multiple variants. The options may be chosen on the product page -

Anti-Cytokeratin 13 (CK13), Clone KRT13/2213
Price range: $269.00 through $1,339.00 Select options This product has multiple variants. The options may be chosen on the product page -

Anti-C4D, Clone Polyclonal
Price range: $269.00 through $1,455.00 Select options This product has multiple variants. The options may be chosen on the product page -

Anti-CD27
Read more -

Anti-CD27
Price range: $250.00 through $1,685.00 Select options This product has multiple variants. The options may be chosen on the product page -

Anti-CEACAM1
Read more -

Anti-CEACAM1
Price range: $250.00 through $1,599.00 Select options This product has multiple variants. The options may be chosen on the product page -

Anti-CD117/c-Kit/SCF-Receptor
Price range: $250.00 through $1,235.00 Select options This product has multiple variants. The options may be chosen on the product page

